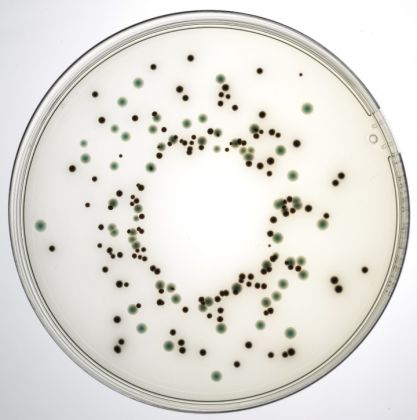

BPW-HQ – Bouillon denrichissement pour Neogen Salmonella One-Broth-One-Plate méthode validée ISO16140
- Format: 3 x 3000 ml Bags
- Code: NCM3402
- Technologie: Gélose chromogène
- Application: Analyses microbiologiques
- Tags / Filtre: Salmonella
NEOGEN a développé une solution de flux de travail innovante pour la détection d'agents pathogènes dans les échantillons alimentaires et environnementaux, en utilisant un seul bouillon d'enrichissement et une plaque de gélose. Idéal pour les laboratoires qui cherchent à réduire le délai d'obtention des résultats tout en conservant la microbiologie classique, les flux de travail One-Broth-One-Plate (OBOP) ont une sensibilité accrue par rapport aux méthodes ISO correspondantes, avec des résultats en aussi peu que 48 heures. Une sensibilité accrue est obtenue grâce à l'étape d'enrichissement propriétaire de chaque flux de travail. Les flux de travail OBOP, disponibles pour la détection de Listeria spp., Listeria monocytogenes et Salmonella spp., ont été indépendamment validés et certifiés selon la norme ISO 16140-2, en tant que méthode de test alternative aux méthodes de référence ISO associées. One-Broth-One-Plate for Salmonella (OBOP-S) offre une méthode rapide pour l'enrichissement et la détection de Salmonella spp. en utilisant la méthodologie de la culture traditionnelle. One-Broth-One-Plate for Salmonella utilise le BPW-HQ de Neogen pour une seule étape d'enrichissement nocturne conçue pour récupérer les salmonelles endommagées. La formulation du support de base est conforme à la norme ISO 6579-1:2017. Lorsqu'elle est utilisée conjointement avec le supplément sélectif OBOP-S, l'eau peptonée tamponnée constitue un milieu sélectif pour un flux de travail alternatif à la norme ISO 6579-1:2017. Le supplément sélectif Salmonella est fourni séparément pour permettre l'utilisation commune du milieu comme diluant pour d'autres analyses de cet échantillon avant l'incubation pendant la nuit. La détection se fait via la gélose chromogène pour Salmonella Esterase (CASE), une gélose chromogène sélective pour la détection de Salmonella. Le bouillon est disponible sous forme de poudre déshydratée ou prêt à l'emploi en sachets et flacons de 225 ml.
- Format: 3 x 3000 ml Bags
- Code: NCM3402
- Technologie: Gélose chromogène
- Application: Analyses microbiologiques
- Tags / Filtre: Salmonella